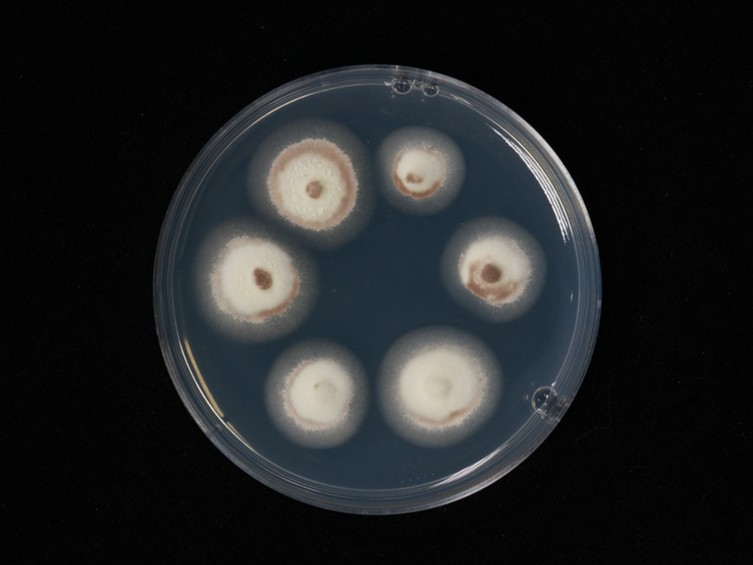

Holotype:
JAPAN.
Habitat:
Leaf litter, underside of leaf.
Host:
Spiders.
Description:
 Host covered with dense weft of pink mycelia, showing a velvety appearance. In early stages the mycelia coming out of the joints in the legs and body eventually fully covered with layers of
Host covered with dense weft of pink mycelia, showing a velvety appearance. In early stages the mycelia coming out of the joints in the legs and body eventually fully covered with layers of  conidiophores. Conidiophores mononematous or (rarely) synnematous, 100–150 × 2–2.5 μm.
conidiophores. Conidiophores mononematous or (rarely) synnematous, 100–150 × 2–2.5 μm.  Phialides borne on the conidiophore or on small side branches, 5–7 × 2–3 μm.
Phialides borne on the conidiophore or on small side branches, 5–7 × 2–3 μm.  Conidia purple-grey, variable in size and shape within individual specimens, 3.5–6 × 1–1.5 μm.
Conidia purple-grey, variable in size and shape within individual specimens, 3.5–6 × 1–1.5 μm.  Stroma arising from head of host, 50–2 mm, composed of a simple stipe and clavate fertile part, cream white. Mycelia covering the whole body of host.
Stroma arising from head of host, 50–2 mm, composed of a simple stipe and clavate fertile part, cream white. Mycelia covering the whole body of host.  Perithecia immersed, elongated flask-shaped, 1000–1300 × 200–300 μm, with the ostioles.
Perithecia immersed, elongated flask-shaped, 1000–1300 × 200–300 μm, with the ostioles.  Asci filiform, hyaline, 570–800 × 4.5–5.5 μm.
Asci filiform, hyaline, 570–800 × 4.5–5.5 μm.  Ascospores filiform, hyaline, multi-septate, easily breaking into part-spores. Part-spores 3–4 ×1–1.5 μm, cylindrical with truncate ends.
Ascospores filiform, hyaline, multi-septate, easily breaking into part-spores. Part-spores 3–4 ×1–1.5 μm, cylindrical with truncate ends.
Culture characteristics:
Colonies on PDA attaining a diam of 10 mm in 14 d. Colonies are floccose, white, changing to grayish-purple when conidial production starts.
PDA attaining a diam of 10 mm in 14 d. Colonies are floccose, white, changing to grayish-purple when conidial production starts.
Reference:
Spatafora JW, Quandt CA, Kepler RM, et al. (2015). New 1F1N Species Combinations in Ophiocordycipitaceae (Hypocreales). IMA Fungus 6: 357–362.
DOI: https://doi.org/10.5598/imafungus.2015.06.02.07Species |
Strain |
Compound |
Pubchem CID |
Biological activity |
Reference |
|---|
|
Strain |
|---|